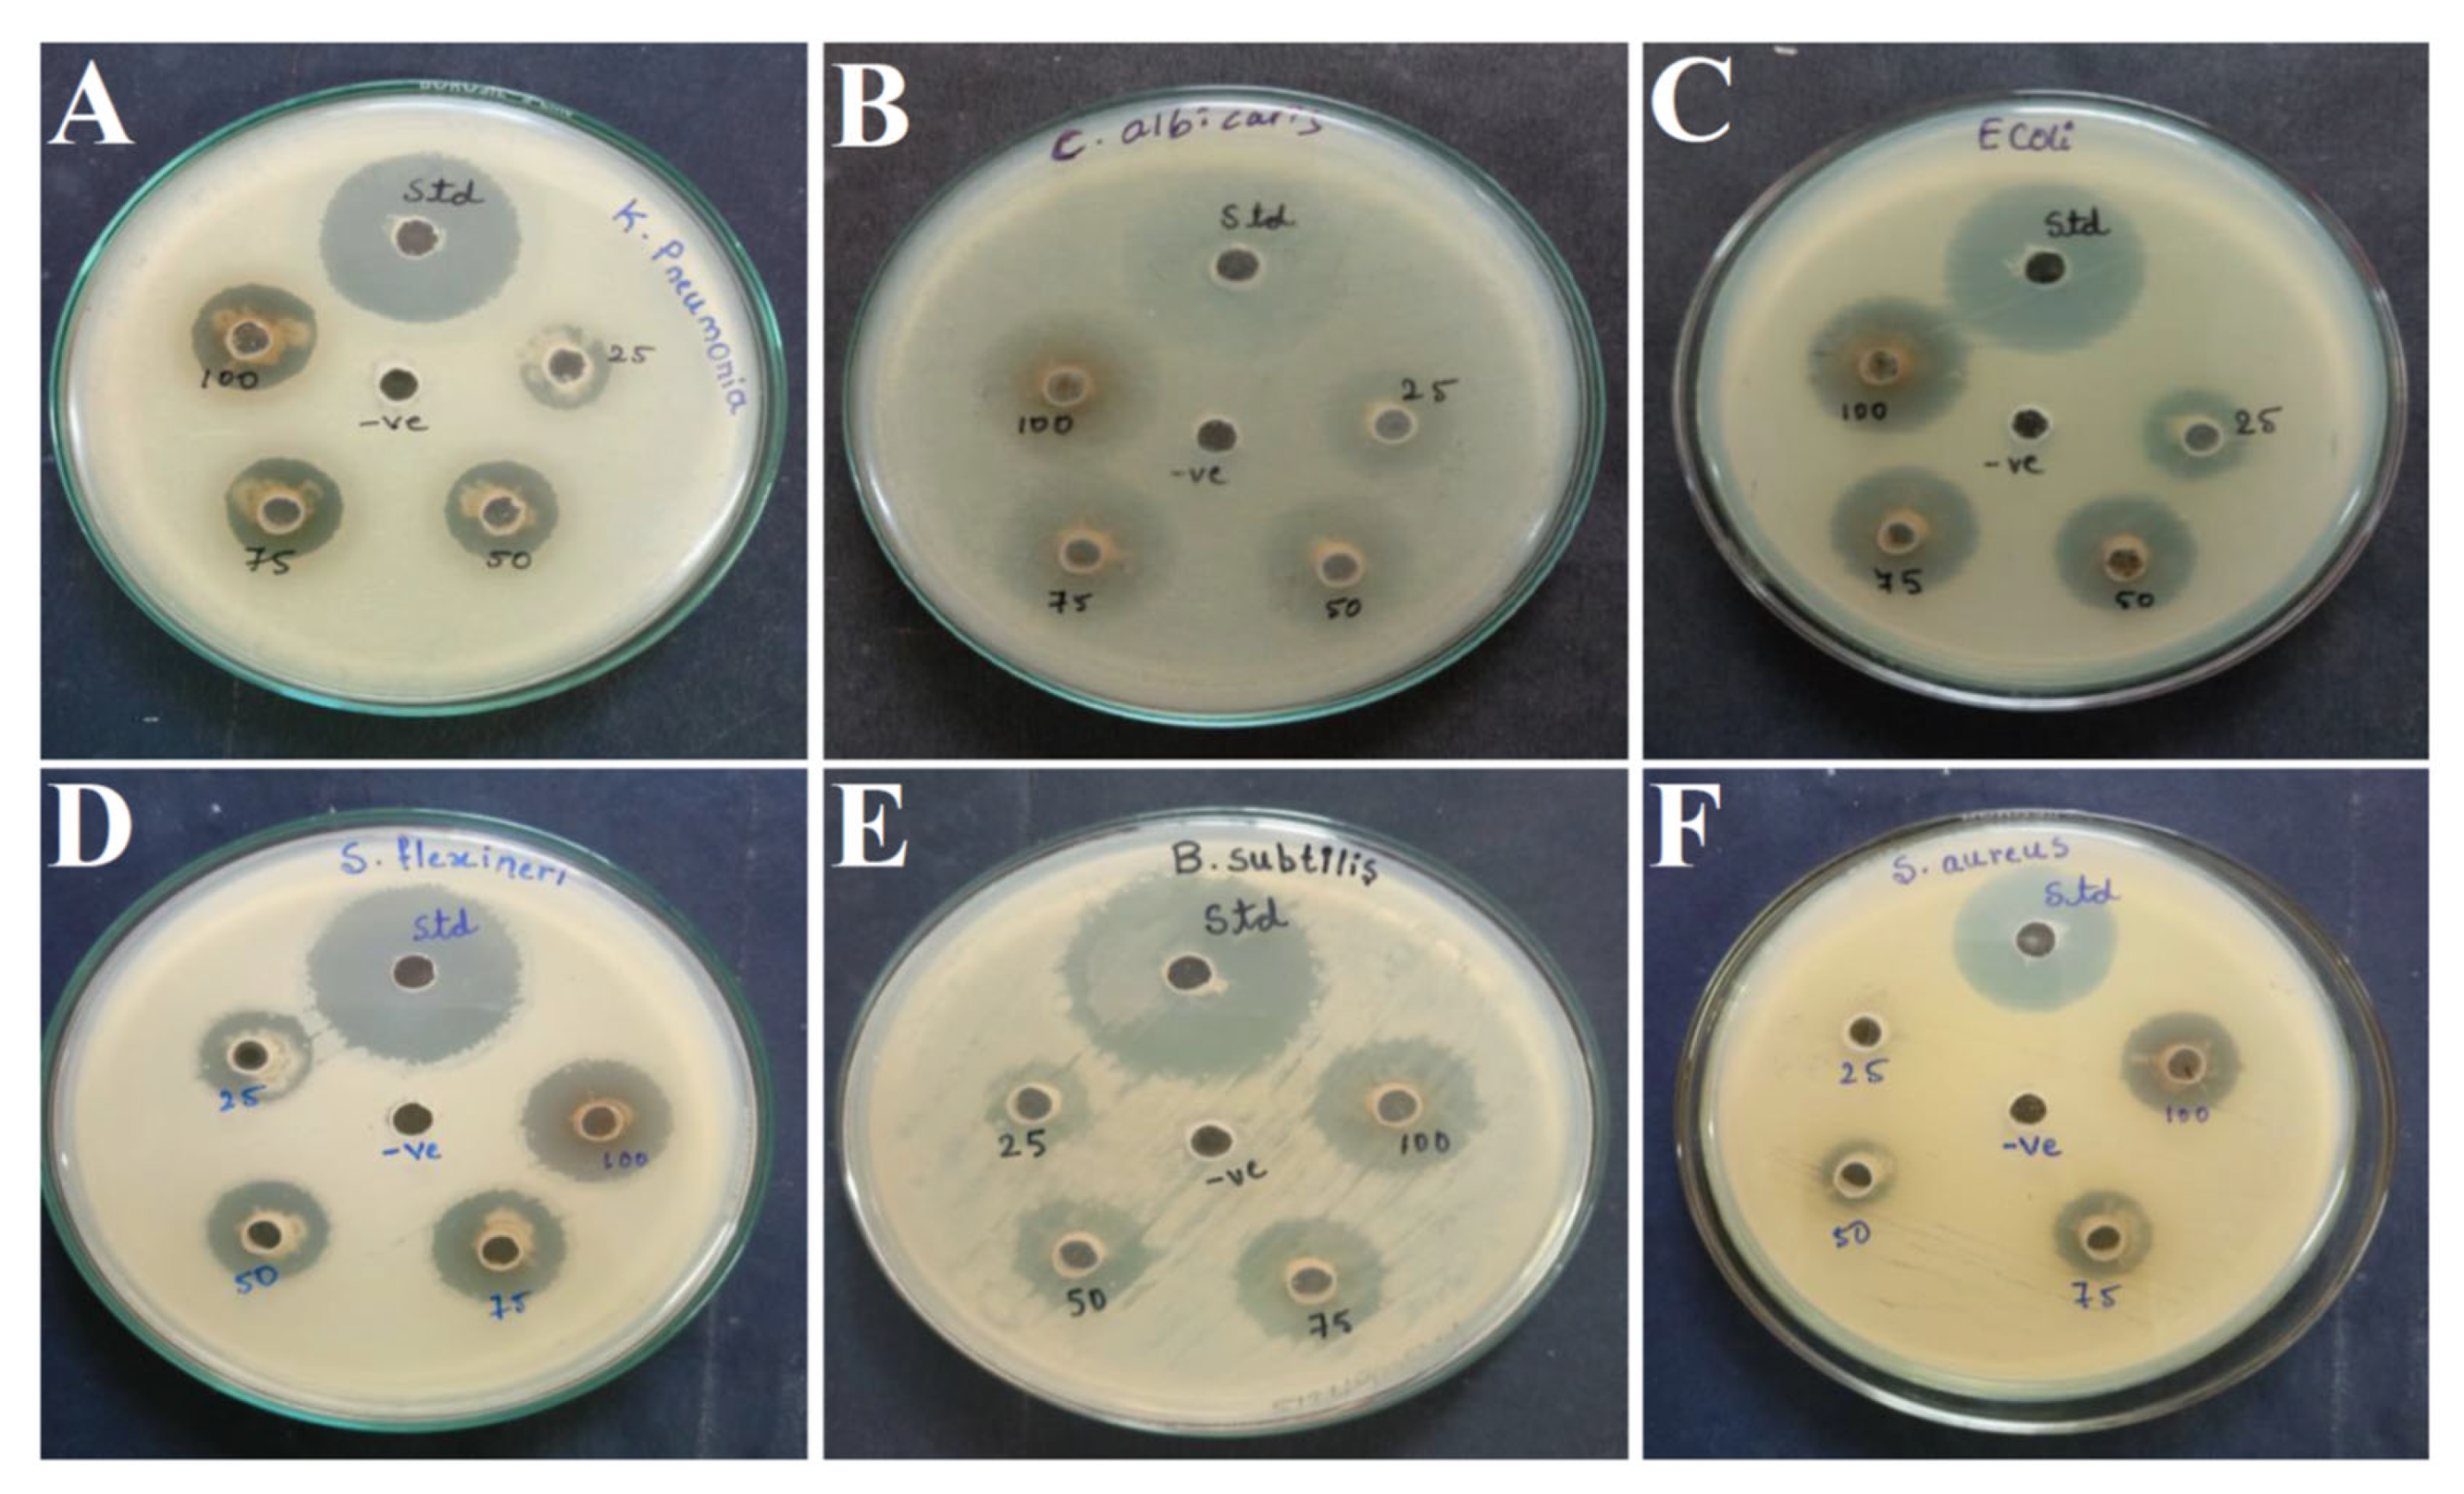
Cimb 45 00241 g003

GC-MS Based Characterization, Antibacterial, Antifungal and Anti-Oncogenic Activity of Ethyl Acetate Extract of Aspergillus niger Strain AK-6 Isolated from Rhizospheric Soil
Abstract
1. Introduction
- Isolation, primary screening, and identification of fungal species isolated from rhizospheric soil;
- Assessment of antimicrobial and antifungal activity of isolated fungal extract (AK-6) against human pathogens and phytopathogens;
- Molecular characterization of potent fungal isolate AK-6. FT-IR and GC-MS analysis of the ethyl acetate extract of isolate AK-6;
- Assessment of the anticancer activity of the ethyl acetate extract of AK-6 using the in vitro cytotoxic assay method against the MCF-7 breast cancer cell line;
- Evaluation of apoptosis inducing efficacy of ethyl acetate extract from AK-6 against the MCF-7 breast cancer cell line by flow cytometric analysis.
2. Materials and Methods
2.1. Collection of Samples, Chemicals, Pathogens, and Cancer Cell Line
2.2. Isolation of Fungi
2.3. Morphological Characterization
2.4. Extraction of Secondary Metabolites
2.5. Antimicrobial Activity of AK-6 Isolate against Human Pathogens
2.6. Antifungal Activity of Isolate AK-6 against Phytopathogens
2.7. Molecular Characterization of Isolate AK-6
2.8. PCR Amplification
2.9. Fourier Transform Infrared Spectroscopy (FTIR) Analysis
2.10. Gas Chromatography Mass Spectroscopy (GC-MS) Analysis
2.11. Anticancer Activity by MTT Assay
2.12. Apoptosis Assay by Flow Cytometry
2.13. Statistical Analysis
3. Results
3.1. Isolation of Fungi and Primary Screening
3.2. Morphological Characterization
3.3. Antimicrobial Activity against Human Pathogens
3.4. Antifungal Activity against Phytopathogens
3.5. Molecular Characterization of Isolate AK-6
3.6. FTIR Analysis
3.7. GC-MS Analysis
3.8. Anticancer Activity: Cell Viability by MTT Assay
3.9. Apoptosis Assay
4. Discussion
5. Conclusions
Author Contributions
Funding
Institutional Review Board Statement
Informed Consent Statement
Data Availability Statement
Acknowledgments
Conflicts of Interest
References
- Cragg, G.M.; Newman, D.J. Biodiversity: A continuing source of novel drug leads. Pure Appl. Chem. 2005, 77, 7–24. [Google Scholar] [CrossRef]
- Shankar, A.; Sharma, K.K. Fungal secondary metabolites in food and pharmaceuticals in the era of multi-omics. Appl. Microbiol. Biotechnol. 2022, 106, 3465–3488. [Google Scholar] [CrossRef] [PubMed]
- Rudrappa, M.; Kumar, R.S.; Nagaraja, S.K.; Hiremath, H.; Gunagambhire, P.V.; Almansour, A.I.; Perumal, K.; Nayaka, S. Myco-Nanofabrication of silver nanoparticles by Penicillium brasilianum NP5 and their antimicrobial, photoprotective and anticancer effect on MDA-MB-231 Breast Cancer Cell Line. Antibiotics 2023, 12, 567. [Google Scholar] [CrossRef]
- Hawksworth, D.L.; Lucking, R. Fungal Diversity Revisited: 2.2 to 3.8 Million Species. Microbiol. Spectr. 2017, 5, 5.4.10. [Google Scholar] [CrossRef] [PubMed]
- Yang, T.; Li, X.; Hu, B.; Wei, D.; Wang, Z.; Bao, W. Soil microbial biomass and community composition along a latitudinal gradient in the arid valleys of southwest China. Geoderma 2022, 413, 115750. [Google Scholar] [CrossRef]
- Bruand, A.; Cousin, I.; Nicoullaud, B.; Duval, O.; Begon, J.C. Backscattered electron scanning images of soil porosity for analyzing soil compaction around roots. Soil Sci. Soc. Am. J. 1996, 60, 895–901. [Google Scholar] [CrossRef]
- Coleine, C.; Stajich, J.E.; Selbmann, L. Fungi are key players in extreme ecosystems. Trends Ecol. Evol. 2022, 37, 517–528. [Google Scholar] [CrossRef]
- Frąc, M.; Weber, J.; Gryta, A.; Dębicka, M.; Kocowicz, A.; Jamroz, E.; Oszust, K.; Żołnierz, L. microbial functional diversity in podzol ectohumus horizons affected by alkaline fly ash in the vicinity of Electric Power Plant. Geomicrobiol. J. 2017, 34, 579–586. [Google Scholar] [CrossRef]
- Conrado, R.; Gomes, T.C.; Roque, G.S.C.; de Souza, A.O. Overview of bioactive fungal secondary metabolites: Cytotoxic and antimicrobial compounds. Antibiotics 2022, 11, 1604. [Google Scholar] [CrossRef] [PubMed]
- Abdel-Aziz, M.S.; Ghareeb, M.A.; Saad, A.M.; Refahy, L.A.; Hamed, A.A. Chromatographic isolation and structural elucidation of secondary metabolites from the soil-inhabiting fungus Aspergillus fumigatus 3T-EGY. Acta Chromatogr. Acta Chromatogr. 2018, 30, 243–249. [Google Scholar] [CrossRef]
- Enyi, E.; Ekpunobi, N. Secondary metabolites from endophytic fungi of Moringa oleifera: Antimicrobial and antioxidant properties. J. Microbiol. Exp. 2022, 10, 150–154. [Google Scholar]
- Al-Fakih, A.A.; Almaqtri, W.Q.A. Overview on antibacterial metabolites from terrestrial Aspergillus spp. Mycology 2019, 10, 191–209. [Google Scholar] [CrossRef] [PubMed]
- Wibowo, M.S.; Julianti, E.; Radzali, M.D. Isolation and antibacterial activity of soil-derived fungi from Taman Botaninegara, Shah Alam, Malaysia. Acta Pharm. Indones. 2017, 42, 18–24. [Google Scholar]
- Rodrigues, J.C.; Lima da Silva, W.; Ribeiro da Silva, D.; Maia, C.R.; Santos Goiabeira, C.V.; Figueiredo Chagas, H.D.; Ayres D’Elia, G.M.; Barbosa Alves, G.S.; Zahner, V.; Nunez, C.V.; et al. Antimicrobial activity of Aspergillus sp. from the Amazon Biome: Isolation of kojic acid. Int. J. Microbiol. 2022, 2022, 4010018. [Google Scholar] [CrossRef] [PubMed]
- Ashoka, G.B.; Shivanna, M.B. Antibacterial, antioxidant, and anticancer activities of Penicillium citrinum Thom. endophytic in Jatropha heynei. J. Appl. Pharm. Sci. 2022, 13, 196–207. [Google Scholar] [CrossRef]
- Alkhulaifi, M.M.; Awaad, A.S.; Al-Mudhayyif, H.A.; Alothman, M.R.; Alqasoumi, S.I.; Zain, S.M. Evaluation of antimicrobial activity of secondary metabolites of fungi isolated from Sultanate Oman soil. Saudi Pharm. J. 2019, 27, 401–405. [Google Scholar] [CrossRef]
- Kaur, N.; Arora, D.S.; Kalia, N.; Kaur, M. Bioactive potential of endophytic fungus Chaetomium globosum and GC-MS analysis of its responsible components. Sci. Rep. 2020, 10, 18792. [Google Scholar] [CrossRef]
- Lubertozzi, D.; Keasling, J.D. Developing Aspergillus as a host for heterologous expression. Biotechnol. Adv. 2009, 27, 53–75. [Google Scholar] [CrossRef]
- Gill, H.; Sykes, E.M.E.; Kumar, A.; Sorensen, J.L. Isolation of bioactive metabolites from soil derived fungus-Aspergillus fumigatus. Microorganisms 2023, 11, 590. [Google Scholar] [CrossRef]
- El-hawary, S.S.; Moawad, A.S.; Bahr, H.S.; Abdelmohsen, U.R.; Mohammed, R. Extra-Natural product diversity from the endophytic fungi of the genus Aspergillus. RSC Adv. 2020, 10, 22058–22079. [Google Scholar] [CrossRef]
- Mokhtar, F.Y.; Abo-El Nasr, A.; Elaasser, M.M.; Elsaba, Y.M. Bioactive secondary metabolites from Aspergillus fumigatus ON428521 isolated from Wadi El Rayan, El Fayum Governorate. Egypt. J. Bot. 2023, 63, 233–250. [Google Scholar] [CrossRef]
- Sunil, D.P.L.N.S.N.; Siddalingeshwara, K.G.; Karthic, J.; Pramod, T.; Vishwanatha, T. Antitumour property l-glutaminase on from Aspergillus oryzae through submergrd fermentation. Int. J. Curr. Microbiol. Appl. Sci. 2014, 3, 819–823. [Google Scholar]
- Supattra, P.; Tongkantom, K.; Jabamrung, P.; Bo-kaew, O.; Soytong, M. Isolation, characterization and screening for anticancer and antimicrobial properties of the crude extract from Genus Neosartorya. Bioeng. Biosci. 2016, 4, 71–75. [Google Scholar]
- Somaida, A.; Tariq, I.; Ambreen, G.; Abdelsalam, A.M.; Ayoub, A.M.; Wojcik, M.; Dzoyem, J.P.; Bakowsky, U. Potent cytotoxicity of four cameroonian plant extracts on different cancer cell lines. Pharmaceuticals 2020, 13, 357. [Google Scholar] [CrossRef] [PubMed]
- Khan, T.; Ali, M.; Khan, A.; Nisar, P.; Jan, S.A.; Afridi, S.; Shinwari, Z.K. Anticancer plants: A review of the active phytochemicals, applications in animal models, and regulatory aspects. Biomolecules 2019, 10, 47. [Google Scholar] [CrossRef]
- Kanjana, M.; Kanimozhi, G.; Udayakumar, R.; Panneerselvam, A. GC-MS analysis of bioactive compounds of endophytic fungi Chaetomium globosum, Cladosporium tenuissimum and Penicillium janthinellum. J. Biomed. Pharm. Sci. 2019, 2, 123. [Google Scholar]
- Farrokhi, Y.; Al-Shibli, B.; Al-Hameedawi, D.F.; Neshati, Z.; Makhdoumi, A. Escherichia coli enhances the virulence factors of Candida albicans, the cause of vulvovaginal candidiasis, in a dual bacterial/fungal biofilm. Res. Microbiol. 2021, 172, 103849. [Google Scholar] [CrossRef]
- Eshima, S.; Kurakado, S.; Matsumoto, Y.; Kudo, T.; Sugita, T. Candida albicans promotes the antimicrobial tolerance of Escherichia coli in a Cross-Kingdom Dual-Species Biofilm. Microorganisms 2022, 10, 2179. [Google Scholar] [CrossRef]
- Hidayat, A.; Turjaman, M.; Faulina, S.A.; Ridwan, F.; Aryanto, A.; Najmulah, N.; Irawadi, T.T.; Iswanto, A.H. Antioxidant and antifungal activity of endophytic fungi associated with agarwood trees. J. Korean Wood Sci. Technol. 2019, 47, 459–471. [Google Scholar] [CrossRef]
- Kumar, S.; Stecher, G.; Tamura, K. MEGA7: Molecular evolutionary genetics analysis version 7.0 for bigger datasets. Mol. Biol. Evol. 2016, 33, 1870–1874. [Google Scholar] [CrossRef]
- Doyle, J.J.; Doyle, J.L. A rapid DNA isolation procedure for small quantities of fresh leaf tissue. Phytochem. Bull. 1987, 19, 11–15. [Google Scholar]
- Saad-Hussein, A.; Soliman, K.M.; Moubarz, G. 18S rRNA gene sequencing for environmental aflatoxigenic fungi and risk of hepatic carcinoma among exposed workers. J. Environ. Sci. Health Part A Toxic/Hazard. Subst. Environ. Eng. 2022, 57, 174–182. [Google Scholar] [CrossRef]
- Bhat, M.P.; Nayaka, S.; Kumar, R.S. A swamp forest Streptomyces sp. strain KF15 with broad spectrum antifungal activity against chilli pathogens exhibits anticancer activity on HeLa cells. Arch. Microbiol. 2022, 204, 540. [Google Scholar] [CrossRef] [PubMed]
- Skanda, S.; Vijayakumar, B. Antioxidant and anti-inflammatory metabolites of a soil-derived fungus Aspergillus arcoverdensis SSSIHL-01. Curr. Microbiol. 2021, 78, 1317–1323. [Google Scholar] [CrossRef] [PubMed]
- Alley, M.C.; Scudiero, D.A.; Monks, A.; Hursey, M.L.; Czerwinski, M.J.; Fine, D.L.; Abbott, B.J.; Mayo, J.G.; Shoemaker, R.H.; Boyd, M.R. Feasibility of drug screening with panels of human tumor cell lines using a microculture tetrazolium assay. Cancer Res. 1988, 48, 589–601. [Google Scholar]
- Aubry, J.-P.; Blaecke, A.; Lecoanet-Henchoz, S.; Jeannin, P.; Herbault, N.; Caron, G.; Moine, V.; Bonnefoy, J.-Y. Annexin V used for measuring apoptosis in the early events of cellular cytotoxicity. Cytometry 1999, 37, 197–204. [Google Scholar] [CrossRef]
- Woese, C.R.; Fox, G.E. Phylogenetic structure of the prokaryotic domain: The primary kingdoms. Proc. Natl. Acad. Sci. USA 1977, 74, 5088–5090. [Google Scholar] [CrossRef]
- Newman, D.J.; Cragg, G.M. Natural products as sources of new drugs from 1981 to 2014. J. Nat. Prod. 2016, 79, 629–661. [Google Scholar] [CrossRef]
- Emmanuel, A.J.; Igoche, O.P. Isolation and characterization of antibiotic producing fungi from soil. Microbiol. Res. J. Int. 2022, 32, 28–40. [Google Scholar] [CrossRef]
- Sethi, S.; Kumar, R.; Gupta, S. Antibiotic production by microbes isolated from soil. Int. J. Pharm. Sci. Res. 2013, 4, 2967. [Google Scholar]
- Purssell, E. Antimicrobials. In Understanding Pharmacology in Nursing Practice; Hood, P., Khan, E., Eds.; Springer International Publishing: Cham, Switzerland, 2020; pp. 147–165. [Google Scholar]
- Schuster, E.; Dunn-Coleman, N.; Frisvad, J.; van Dijck, P. On the safety of Aspergillus niger—A review. Appl. Microbiol. Biotechnol. 2002, 59, 426–435. [Google Scholar] [PubMed]
- Gonçalves, M.F.M.; Hilário, S.; Van de Peer, Y.; Esteves, A.C.; Alves, A. Genomic and Metabolomic Analyses of the Marine Fungus Emericellopsis cladophorae: Insights into saltwater adaptability mechanisms and its biosynthetic potential. J. Fungi 2022, 8, 31. [Google Scholar] [CrossRef] [PubMed]
- Sohail, M.; Zafar, I.; Sheena; Shujaul, M.K.; Inayat, R.; Waqar, K.; Ali, A.; Imran, U.; Muhammad, N. Antimicrobial activity of mycelial extracts of Rhizopus stolonifer against different fungal and bacterial pathogenic strains. Int. J. Biosci. 2014, 4, 183–188. [Google Scholar]
- Rabiyathul, M.A.A.; Kalaiselvam, M. Antibacterial Efficacy of Crude Extracts of Trichoderma spp. Isolated from Mangrove Rhizosphere. Int. Res. J. Pharm. 2017, 8, 70–73. [Google Scholar]
- Alasmary, F.A.S.; Awaad, A.S.; Kamal, M.; Alqasoumi, S.I.; Zain, M.E. Antitumor activity of extract and isolated compounds from Drechslera rostrata and Eurotium tonophilum. Saudi. Pharm. J. 2018, 26, 279–285. [Google Scholar] [CrossRef] [PubMed]
- Salehi, B.; Bayat, M.; Dezfulian, M.; Sabokbar, A.; Tabaraie, B. The assessment of anti-tumoral activity of polysaccharide extracted from terrestrial filamentous fungus. Saudi J. Biol. Sci. 2018, 25, 1236–1241. [Google Scholar] [CrossRef] [PubMed]
- Melo, M.; Araujo, A.; Chogi, M.; Duarte, I. Cellulolytic and lipolytic fungi isolated from soil and leaf litter samples from the Cerrado (Brazilian Savanna). Rev. Biol. Trop. 2018, 66, 237–245. [Google Scholar] [CrossRef]
- Makut, M.; Owolewa, O. Antibiotic-producing fungi present in the soil environment of Keffi Metropolis, Nasarawa State, Nigeria. Trakia J. Sci. 2011, 9, 33–39. [Google Scholar]
- Zulqarnain; Iqbal, Z.; Cox, R.; Anwar, J.; Ahmad, N.; Khan, K.; Iqbal, M.; Manzoor, N.; Khattak, S.U. Antifungal activity of compounds isolated from Aspergillus niger and their molecular docking studies with tomatinase. Nat. Prod. Res. 2020, 34, 2642–2646. [Google Scholar] [CrossRef]
- Song, Z.; Sun, Y.J.; Xu, S.; Li, G.; Yuan, C.; Zhou, K. Secondary metabolites from the Endophytic fungi Fusarium decemcellulare F25 and their antifungal activities. Front. Microbiol. 2023, 14, 1127971. [Google Scholar] [CrossRef]
- Marei, G.I.K.; Samir, A.M.A. Antifungal potential and biochemical effects of monoterpenes and phenylpropenes on plant pathogenic fungi. Plant Protect. Sci 2018, 54, 9–16. [Google Scholar] [CrossRef]
- Awad, M.F.; Albogami, B.; Mwabvu, T.; Hassan, M.M.; Baazeem, A.; Hassan, M.M.; Elsharkawy, M.M. Identification and biodiversity patterns of Aspergillus species isolated from some soil invertebrates at high altitude using morphological characteristics and phylogenetic analyses. PeerJ 2023, 11, e15035. [Google Scholar] [CrossRef] [PubMed]
- Waing, K.G.D.; Gutierrez, J.M.; Galvez, C.T.; Undan, J.R. Molecular identification of leaf litter fungi potential for cellulose degradation. Mycosphere 2015, 6, 139–144. [Google Scholar] [CrossRef]
- Nayaka, S.; Chakraborty, B.; Swamy, P.S.; Bhat, M.P.; Airodagi, D.; Basavarajappa, D.S.; Rudrappa, M.; Hiremath, H.; Nagaraja, S.K.; Madhappa, C. Isolation, characterization, and functional groups analysis of Pseudoxanthomonas indica RSA-23 from rhizosphere soil. J. Appl. Pharm. Sci. 2019, 9, 101–106. [Google Scholar]
- Bhat, R. Potential use of fourier transform infrared spectroscopy for identification of molds capable of producing mycotoxins. Int. J. Food Prop. 2013, 16, 1819–1829. [Google Scholar] [CrossRef]
- Uras, I.S.; Karsli, B.; Konuklugil, B.; Ocsoy, I.; Demirbas, A. Organic–inorganic nanocomposites of Aspergillus terreus extract and its compounds with antimicrobial properties. Sustainability 2023, 15, 4638. [Google Scholar] [CrossRef]
- Madhusudan, T.; Chander, M.P. GC-MS analysis and in-vitro antibacterial activities of mangrove endophytic fungi. Bangladesh J. Pharmacol. 2023, 18, 36–39. [Google Scholar]
- Wang, L.S.; Liu, H.J.; Zhang, J.H.; Wu, C.T. Purging effect of dibutyl phthalate on leukemia cells involves fas independent activation of caspase-3/CPP32 protease. Cancer Lett. 2002, 186, 177–182. [Google Scholar] [CrossRef]
- Supardy, N.A.; Ibrahim, D.; Sulaiman, S.F.; Zakaria, N.A. Inhibition of Klebsiella pneumoniae ATCC 13883 cells by hexane extract of Halimeda discoidea (Decaisne) and the identification of its potential bioactive compounds. J. Microbiol. Biotechnol. 2012, 22, 872–881. [Google Scholar] [CrossRef]
- Mishra, V.K.; Passari, A.K.; Chandra, P.; Leo, V.V.; Kumar, B.; Uthandi, S.; Thankappan, S.; Gupta, V.K.; Singh, B.P. Determination and production of antimicrobial compounds by Aspergillus clavatonanicus strain MJ31, an endophytic fungus from Mirabilis jalapa L. using UPLC-ESI-MS/MS and TD-GC-MS analysis. PLoS ONE 2017, 12, e0186234. [Google Scholar] [CrossRef]
- Shamili, G.S.G. Identification and characterization of bioactive compounds of leaves of Justicia Gendarussa Burm. F. Int. J. Sci. Res. Biol. Sci. 2019, 6, 145–153. [Google Scholar] [CrossRef]
- Wijayanti, D.R.; Dewi, A.P. Extraction and identification potent antibacterial bioactive compound of Streptomyces sp. MB 106 from Euphorbia sp. Rhizosphere. Bioeduscience 2022, 6, 84–88. [Google Scholar]
- Li, Y.; Qiao, H.; Zhang, R.; Zhang, W.; Wen, P. Microbial Diversity and Volatile Flavor Compounds in Tibetan Flavor Daqu. Foods 2023, 12, 324. [Google Scholar] [CrossRef] [PubMed]
- Moubasher, H. Anticancer Compounds from Chaetomium globosum. Biochem. Anal. Biochem. 2015, 4, 2. [Google Scholar]
- Abutaha, N.; Semlali, A.; Baabbad, A.; Al-Shami, M.; Alanazi, M.; Wadaan, M.A. Anti-proliferative and anti-inflammatory activities of entophytic Penicillium crustosum from Phoenix dactylifer. Pak. J. Pharm. Sci. 2018, 31, 1–7. [Google Scholar]
- Yodsing, N.; Lekphrom, R.; Sangsopha, W.; Aimi, T.; Boonlue, S. Secondary metabolites and their biological activity from Aspergillus aculeatus KKU-CT2. Curr. Microbiol. 2018, 75, 513–518. [Google Scholar] [CrossRef]
- Dhayanithy, G.; Subban, K.; Chelliah, J. Diversity and biological activities of endophytic fungi associated with Catharanthus roseus. BMC Microbiol. 2019, 19, 1–14. [Google Scholar] [CrossRef] [PubMed]
- Mousa, A.A.A.; Mohamed, H.; Hassane, A.M.A.; Abo-Dahab, N.F. Antimicrobial and cytotoxic potential of an endophytic fungus Alternaria tenuissima AUMC14342 isolated from Artemisia judaica L. growing in Saudi Arabia. J. King Saud Univ.-Sci. 2021, 33, 101462. [Google Scholar] [CrossRef]
- Sajna, K.; Kamat, S.; Jayabaskaran, C. Antiproliferative role of secondary metabolites from Aspergillus unguis AG 1.1 (G) isolated from marine macroalgae Enteromorpha sp. by inducing intracellular ros production and mitochondrial membrane potential loss leading to apoptosis. Front. Mar. Sci. 2020, 7, 543523. [Google Scholar] [CrossRef]
- Seenivasan, A.; Manikkam, R.; Kaari, M.; Sahu, A.K.; Said, M.; Dastager, S.G. 2, 4-Di-tert-butylphenol (2,4-DTBP) purified from Streptomyces sp. KCA1 from Phyllanthus niruri: Isolation, characterization, antibacterial and anticancer properties. J. King. Saud. Univ. Sci. 2022, 34, 102088. [Google Scholar] [CrossRef]
- Hendy, M.H.; Hashem, A.H.; Suleiman, W.B.; Sultan, M.H.; Abdelraof, M. Purification, characterization and anticancer activity of L-methionine γ-lyase from thermo-tolerant Aspergillus fumigatus. Microb. Cell Factories 2023, 22, 8. [Google Scholar] [CrossRef]
- Tomikawa, T.; Shin-Ya, K.; Furihata, K.; Kinoshita, T.; Miyajima, A.; Seto, H.; Hayakawa, Y. Rasfonin, a new apoptosis inducer in ras-dependent cells from Talaromyces sp. J. Antibiot. 2000, 53, 848–850. [Google Scholar] [CrossRef] [PubMed]
- Bae, S.Y.; Liao, L.; Park, S.H.; Kim, W.K.; Shin, J.; Lee, S.K. Antitumor activity of Asperphenin A, a lipopeptidyl benzophenone from marine-derived Aspergillus sp. fungus, by inhibiting tubulin polymerization in colon cancer cells. Mar. Drugs 2020, 18, 110. [Google Scholar] [CrossRef] [PubMed]
- Prabhu, A.; Venkat, P.; Gajaraj, B.; Nadumane, V.K. Induction of apoptosis in the cervical cancer cell line HeLa by a novel metabolite extracted from the fungus Aspergillus japonicus Saito. Turk. J. Biol. 2014, 38, 922–929. [Google Scholar] [CrossRef]
- Ghfar, A.A.; El-Metwally, M.M.; Shaaban, M.; Gabr, S.A.; Gabr, N.S.; Diab, M.S.; Aqel, A.; Habila, M.A.; Al-Qahtani, W.H.; Alfaifi, M.Y. Production of Terretonin N and Butyrolactone I by Thermophilic Aspergillus terreus TM8 promoted apoptosis and cell death in human prostate and ovarian cancer cells. Molecules 2021, 26, 2816. [Google Scholar] [CrossRef]

| Tukey’s Multiple Comparison Test | Mean Diff. | 95.00% CI of Diff. | Below Threshold? | Summary | Adjusted p Value |
|---|---|---|---|---|---|
| 25 µL | |||||
| C. albicans vs. E. coli | 1.423 | 0.4702 to 2.376 | Yes | *** | 0.0006 |
| C. albicans vs. B. subtilis | 1.217 | 0.2636 to 2.170 | Yes | ** | 0.005 |
| C. albicans vs. S. aureus | 14.33 | 13.38 to 15.29 | Yes | **** | <0.0001 |
| E. coli vs. S. flexneri | −2.05 | −3.003 to −1.097 | Yes | **** | <0.0001 |
| E. coli vs. S. aureus | 12.91 | 11.96 to 13.86 | Yes | **** | <0.0001 |
| S. flexneri vs. B. subtilis | 1.843 | 0.8902 to 2.796 | Yes | **** | <0.0001 |
| S. flexneri vs. S. aureus | 14.96 | 14.01 to 15.91 | Yes | **** | <0.0001 |
| B. subtilis vs. S. aureus | 13.12 | 12.16 to 14.07 | Yes | **** | <0.0001 |
| 50 µL | |||||
| K. pneumoniae vs. S. flexneri | −3.037 | −3.990 to −2.084 | Yes | **** | <0.0001 |
| C. albicans vs. S. flexneri | 1.12 | 0.1669 to 2.073 | Yes | * | 0.0123 |
| C. albicans vs. B. subtilis | 2.063 | 1.110 to 3.016 | Yes | **** | <0.0001 |
| E. coli vs. B. subtilis | 1.73 | 0.7769 to 2.683 | Yes | **** | <0.0001 |
| E. coli vs. S. aureus | 6.84 | 5.887 to 7.793 | Yes | **** | <0.0001 |
| S. flexneri vs. S. aureus | 6.053 | 5.100 to 7.006 | Yes | **** | <0.0001 |
| B. subtilis vs. S. aureus | 5.11 | 4.157 to 6.063 | Yes | **** | <0.0001 |
| 75 µL | |||||
| K. pneumoniae vs. S. flexneri | −3.27 | −4.223 to −2.317 | Yes | **** | <0.0001 |
| K. pneumoniae vs. S. aureus | 1.03 | 0.07689 to 1.983 | Yes | * | 0.0268 |
| C. albicans vs. S. aureus | 4.933 | 3.980 to 5.886 | Yes | **** | <0.0001 |
| E. coli vs. S. aureus | 4.86 | 3.907 to 5.813 | Yes | **** | <0.0001 |
| S. flexneri vs. S. aureus | 4.3 | 3.347 to 5.253 | Yes | **** | <0.0001 |
| B. subtilis vs. S. aureus | 4.27 | 3.317 to 5.223 | Yes | **** | <0.0001 |
| 100 µL | |||||
| K. pneumoniae vs. E. coli | −3.017 | −3.970 to −2.064 | Yes | **** | <0.0001 |
| K. pneumoniae vs. S. flexneri | −2.657 | −3.610 to −1.704 | Yes | **** | <0.0001 |
| C. albicans vs. E. coli | 1.043 | 0.09022 to 1.996 | Yes | * | 0.024 |
| C. albicans vs. S. aureus | 3.157 | 2.204 to 4.110 | Yes | **** | <0.0001 |
| E. coli vs. B. subtilis | −1.187 | −2.140 to −0.2336 | Yes | ** | 0.0067 |
| S. flexneri vs. B. subtilis | −1.547 | −2.500 to −0.5936 | Yes | *** | 0.0002 |
| Absorption | Peak Appearance | Group | Compound Class |
|---|---|---|---|
| 3437.24 | Medium | O–H stretching | Alcohol |
| 2923.96 | Sharp | C–H stretching | Alkane |
| 2852.40 | Sharp | C–H stretching | Alkane |
| 1612.04 | Strong bond | C=C stretching | α, β-Unsaturated ketone |
| 1497.19 | Weak | N–O stretching | Nitro compound |
| 1458.47 | Medium | C–H bending | Alkane |
| 1384.27 | Strong | S=O stretching | Sulfate |
| 1251.92 | Medium | C–N stretching | Alkyl aryl ether |
| 1120.97 | Weak | C–O stretching | Aliphatic ether |
| 549.67 | Medium | C–I stretching | Halo compound |
| Peak | Retention Time | Peak Area % | Compound Name | Molecular Formula | Molecular Weight |
|---|---|---|---|---|---|
| 1 | 11.069 | 7.02 | 1-Dodecene | C10H21CH=CH2 | 168.32 |
| 2 | 13.398 | 2.13 | Tetradecane | C14H3O | 198.39 |
| 3 | 16.344 | 1.67 | Cyclodecane | (CH2)12 | 168.32 |
| 4 | 19.517 | 8.60 | 2,4-Ditert-butylphenol | C14H22O | 204.32 |
| 5 | 25.615 | 7.77 | E-14-Hexadecenal | C16H30O | 3238.41 |
| 6 | 27.340 | 23.82 | N-didehydrohexacarboxyl-2,4,5-trimethylpiperazine | C13H22N2O | 222 |
| 7 | 29.207 | 14.65 | Dibutyl phthalate | C16H22O4 | 278.34 |
| 8 | 29.602 | 8.98 | E-15-Heptadecenal | C17H32O | 252.43 |
| 9 | 33.252 | 6.01 | 1-Heneicosanol | C2H44O | 312.58 |
| 10 | 36.614 | 2.35 | Trifluroacetoxy hexadecane | C18H33F3O2 | 338.4 |
| 11 | 37.995 | 3.05 | Cyclopentane, heneicosyl | C26H52 | 364.7 |
| 12 | 43.141 | 6.16 | Squalene | C30H50 | 410.7 |
| 13 | 44.014 | 2.89 | Tricosane | C23H48 | 324.63 |
| 14 | 45.467 | 2.74 | Nonadecane | C19H40 | 268.518 |
| 15 | 47.184 | 2.16 | Octadecane, 2 methyl | C19H40 | 268.52 |
| Cell Condition | Necrotic Cells (UL) | Late Apoptosis (UR) | Viable Cells (LL) | Early Apoptosis (LR) |
|---|---|---|---|---|
| Untreated | 0 | 0 | 100 | 0 |
| Positive control | 3.97% | 21.33 | 42.77 | 31.93 |
| AK6 | 3.16 | 26.43 | 53.11 | 17.3 |
Disclaimer/Publisher’s Note: The statements, opinions and data contained in all publications are solely those of the individual author(s) and contributor(s) and not of MDPI and/or the editor(s). MDPI and/or the editor(s) disclaim responsibility for any injury to people or property resulting from any ideas, methods, instructions or products referred to in the content. |
© 2023 by the authors. Licensee MDPI, Basel, Switzerland. This article is an open access article distributed under the terms and conditions of the Creative Commons Attribution (CC BY) license (https://creativecommons.org/licenses/by/4.0/).
Share and Cite
Niazi, S.K.; Basavarajappa, D.S.; Kumaraswamy, S.H.; Bepari, A.; Hiremath, H.; Nagaraja, S.K.; Rudrappa, M.; Hugar, A.; Cordero, M.A.W.; Nayaka, S. GC-MS Based Characterization, Antibacterial, Antifungal and Anti-Oncogenic Activity of Ethyl Acetate Extract of Aspergillus niger Strain AK-6 Isolated from Rhizospheric Soil. Curr. Issues Mol. Biol. 2023, 45, 3733-3756. https://doi.org/10.3390/cimb45050241
Niazi SK, Basavarajappa DS, Kumaraswamy SH, Bepari A, Hiremath H, Nagaraja SK, Rudrappa M, Hugar A, Cordero MAW, Nayaka S. GC-MS Based Characterization, Antibacterial, Antifungal and Anti-Oncogenic Activity of Ethyl Acetate Extract of Aspergillus niger Strain AK-6 Isolated from Rhizospheric Soil. Current Issues in Molecular Biology. 2023; 45(5):3733-3756. https://doi.org/10.3390/cimb45050241
Chicago/Turabian StyleNiazi, Shaik Kalimulla, Dhanyakumara Shivapoojar Basavarajappa, Sushma Hatti Kumaraswamy, Asmatanzeem Bepari, Halaswamy Hiremath, Shashiraj Kariyellappa Nagaraja, Muthuraj Rudrappa, Anil Hugar, Mary Anne Wong Cordero, and Sreenivasa Nayaka. 2023. "GC-MS Based Characterization, Antibacterial, Antifungal and Anti-Oncogenic Activity of Ethyl Acetate Extract of Aspergillus niger Strain AK-6 Isolated from Rhizospheric Soil" Current Issues in Molecular Biology 45, no. 5: 3733-3756. https://doi.org/10.3390/cimb45050241
APA StyleNiazi, S. K., Basavarajappa, D. S., Kumaraswamy, S. H., Bepari, A., Hiremath, H., Nagaraja, S. K., Rudrappa, M., Hugar, A., Cordero, M. A. W., & Nayaka, S. (2023). GC-MS Based Characterization, Antibacterial, Antifungal and Anti-Oncogenic Activity of Ethyl Acetate Extract of Aspergillus niger Strain AK-6 Isolated from Rhizospheric Soil. Current Issues in Molecular Biology, 45(5), 3733-3756. https://doi.org/10.3390/cimb45050241

